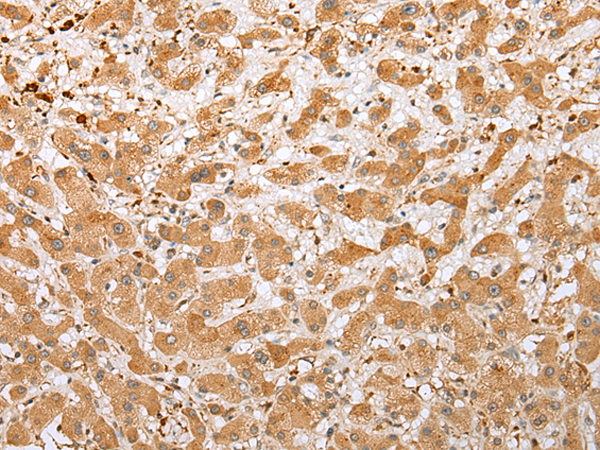
一抗

中文名稱:兔抗NDUFB3多克隆抗體
英文名稱: Anti-NDUFB3 rabbit polyclonal antibody
別 名: B12; CI-B12
相關類別: 一抗
儲 存: 冷凍(-20℃)
宿 主: Rabbit
抗 原: NDUFB3
反應種屬: Human
標 記 物: Unconjugate
克隆類型: rabbit polyclonal
技術規格
|
Background: |
This gene encodes an accessory subunit of the mitochondrial membrane respiratory chain NADH dehydrogenase (Complex I) which is the first enzyme in the electron transport chain of mitochondria. This protein localizes to the inner membrane of the mitochondrion as a single-pass membrane protein. Mutations in this gene contribute to mitochondrial complex 1 deficiency. |
|
Applications: |
ELISA, WB, IHC |
|
Name of antibody: |
NDUFB3 |
|
Immunogen: |
Full length fusion protein |
|
Full name: |
NADH dehydrogenase (ubiquinone) 1 beta subcomplex, 3, 12kDa |
|
Synonyms: |
B12; CI-B12 |
|
SwissProt: |
O43676 |
|
ELISA Recommended dilution: |
5000-10000 |
|
IHC positive control: |
Human liver cancer |
|
IHC Recommend dilution: |
25-100 |
|
WB Predicted band size: |
11 kDa |
|
WB Positive control: |
Hela, PC3 and 293T cell |
|
WB Recommended dilution: |
500-2000 |


 購物車
購物車 幫助
幫助
 021-54845833/15800441009
021-54845833/15800441009